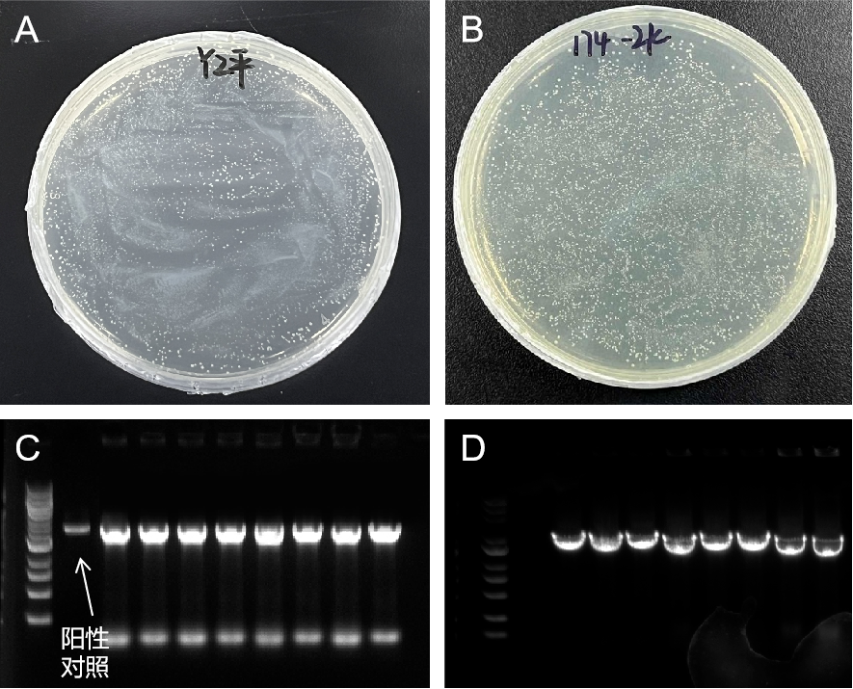
新闻图片2
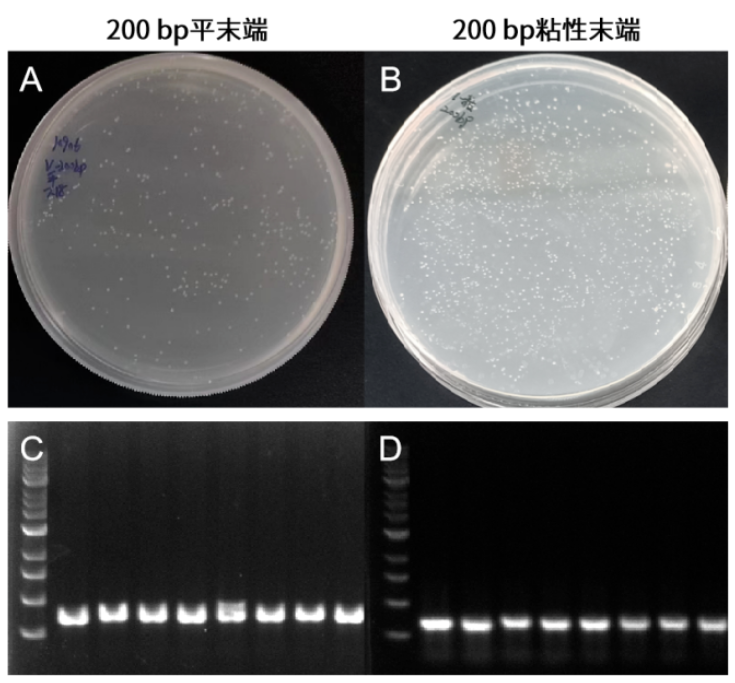
新闻图片5
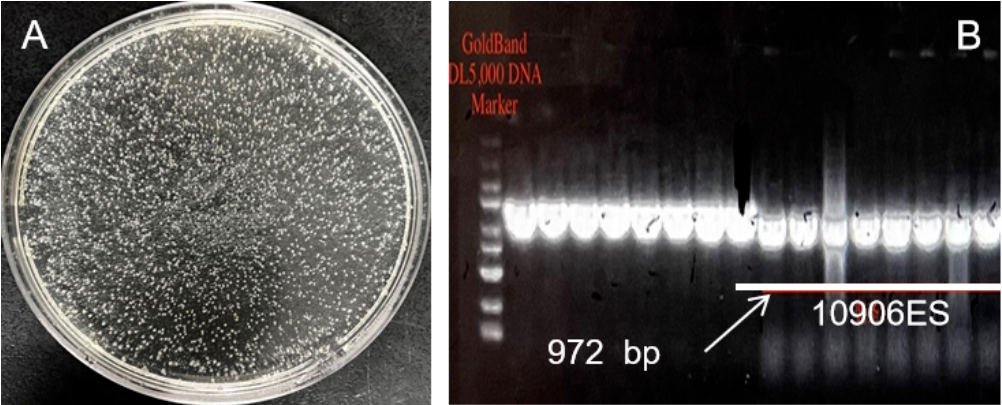
新闻图片9
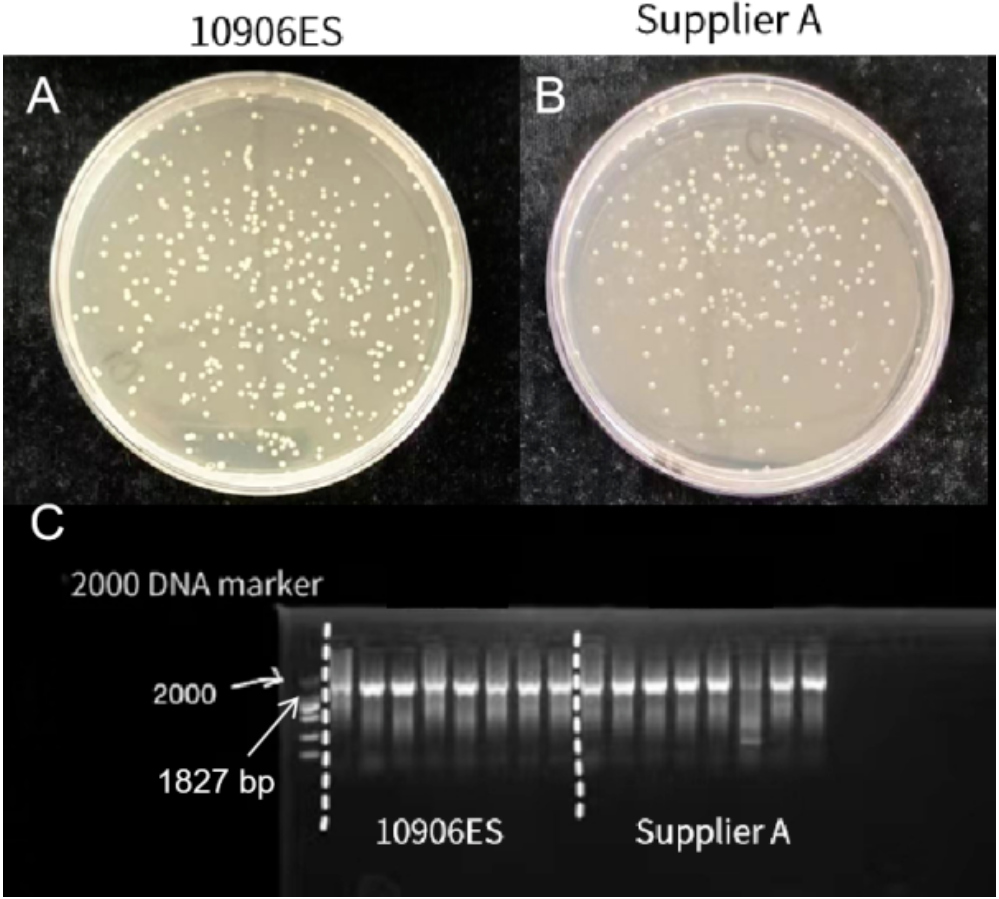
新闻图片10
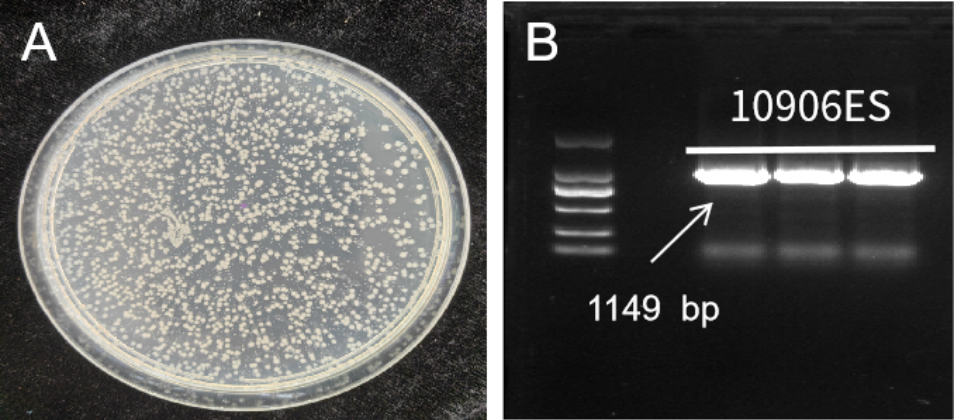
新闻图片13
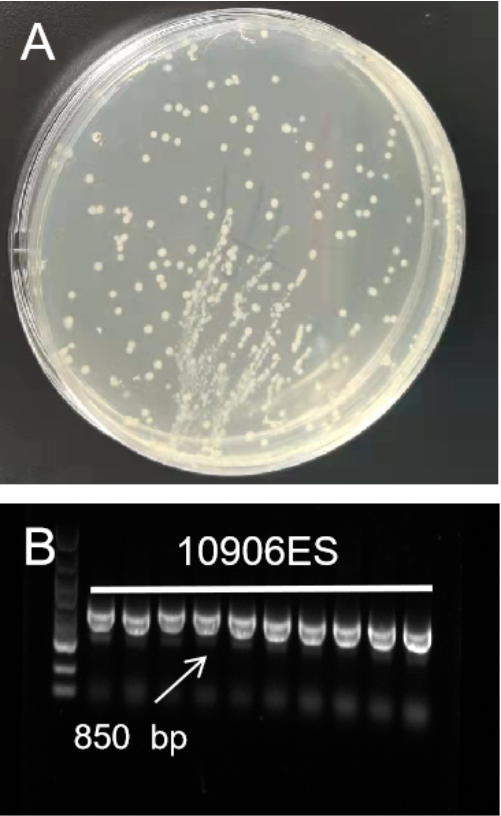
新闻图片14
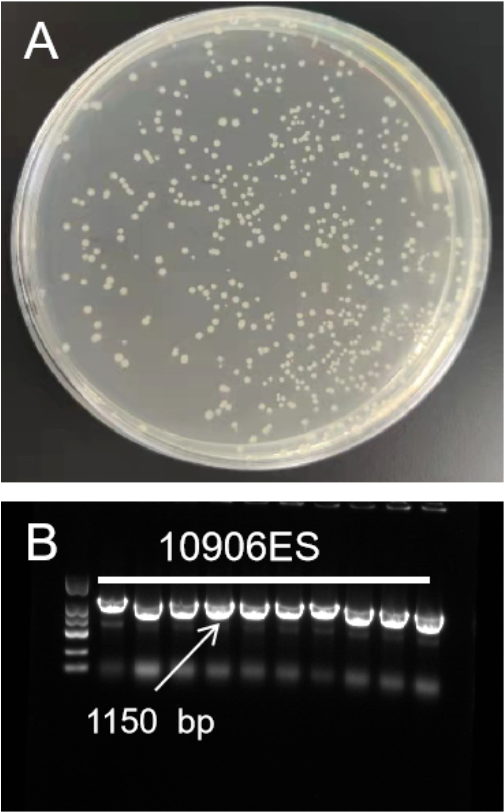
新闻图片15
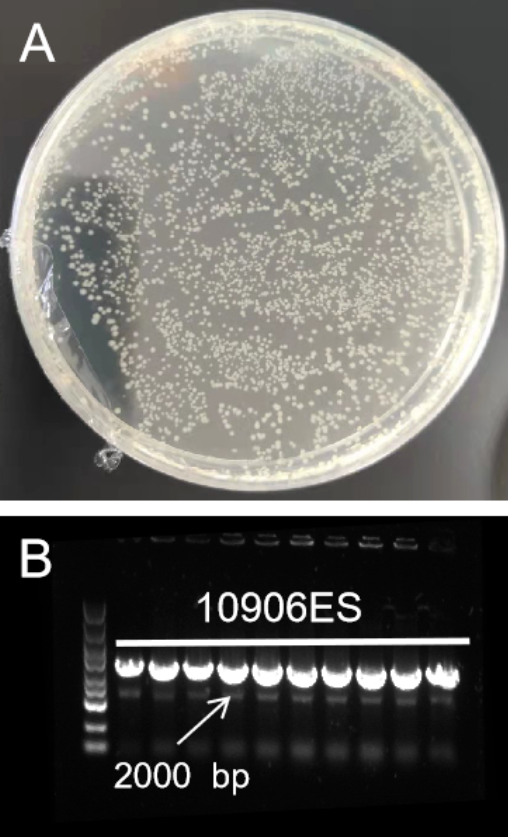
新闻图片16

19 年
手机商铺
入驻年限:19 年
翌圣生物
上海
体外诊断、耗材、技术服务、抗体、ELISA 试剂盒、细胞库 / 细胞培养、试剂
生产厂商
公司新闻/正文
542 人阅读发布时间:2023-10-16 09:39
产品名称 Hieff Clone® Universal Zero TOPO TA/Blunt Cloning Kit
产品特点
快速:仅需5分钟即可完成连接反应;
高效:无自连现象,阳性克隆率接近100%,无需设置蓝白斑筛选;
连接片段:可连接150 bp-5 kb目的产物;
简便:只需加入纯化后目的片段即可;
兼容性广:添加平末端因子,兼容TA克隆与平末端克隆。
操作流程

产品实例 兼容平末端/粘性末端片段
注:A)TOPO克隆转化平板;B)插入片段PCR鉴定电泳图
投入200 ng 、4 kb的平末端片段,Hieff Clone® Universal Zero TOPO TA/Blunt Cloning Kit连接效率高,菌落数多,阳性率达100%。

注:A&B)TOPO克隆转化平板。C&D)插入片段PCR鉴定电泳图
投入10 ng、2 kb的平末端/粘性末端片段,Hieff Clone® Universal Zero TOPO TA/Blunt Cloning Kit连接效率高,菌落数多,阳性率达100%。

注:A)TOPO克隆转化平板;B)插入片段PCR鉴定电泳图
投入10 ng、1 kb的平末端/粘性末端片段,Hieff Clone® Universal Zero TOPO TA/Blunt Cloning Kit连接效率高,菌落数多,阳性率达100%。
注:A)TOPO克隆转化平板;B)插入片段PCR鉴定电泳图
投入10 ng 、200 bp的平末端/粘性末端片段,Hieff Clone® Universal Zero TOPO TA/Blunt Cloning Kit连接效率高,菌落数多,阳性率达100%。
试剂盒稳定性好

注:A&C)分别为37℃条件下放置0、3、5、7天的TOPO克隆转化平板;B&D)插入片段PCR鉴定电泳图
在37℃条件下放置7天,Hieff Clone® Universal Zero TOPO TA/Blunt Cloning Kit试剂盒依旧稳定。

注:A)分别为冻融10次、20次、50次的TOPO克隆转化平板;B)插入片段PCR鉴定电泳图
反复冻融50次,Hieff Clone® Universal Zero TOPO TA/Blunt Cloning Kit试剂盒依旧稳定。
客户案例 平末端片段
试剂盒连接不同来源的平末端片段,成功率近100%。

注:A&B)载体和片段均来自南京某高校;C)插入片段PCR鉴定电泳图
Hieff Clone® Universal Zero TOPO TA/Blunt Cloning Kit连接900 bp(180 ng)平末端片段图。
注:A)载体和片段均来自南京某高校;B)插入片段PCR鉴定电泳图
Hieff Clone® Universal Zero TOPO TA/Blunt Cloning Kit连接972 bp(80 ng)平末端片段图。
注:A&B)载体和片段均来自南京某高校;C)插入片段PCR鉴定电泳图
Hieff Clone® Universal Zero TOPO TA/Blunt Cloning Kit连接1827 bp(90 ng)平末端片段图。

注:A)载体和片段均来自广州某高校;B)插入片段PCR鉴定电泳图
Hieff Clone® Universal Zero TOPO TA/Blunt Cloning Kit连接1350 bp(35 ng)平末端片段图。

注:A)载体和片段均来自中国农业科学院某研究所;B)插入片段PCR鉴定电泳图
Hieff Clone® Universal Zero TOPO TA/Blunt Cloning Kit连接3000 bp(55 ng)平末端片段图。
注:A)载体和片段均来自南京某高校;B)插入片段PCR鉴定电泳图
Hieff Clone® Universal Zero TOPO TA/Blunt Cloning Kit连接1149 bp(200 ng)平末端片段图。
粘性末端片段
试剂盒连接不同来源的粘性末端片段,成功率近100%。
注:A)载体和片段均来自南京某高校;B)插入片段PCR鉴定电泳图
Hieff Clone® Universal Zero TOPO TA/Blunt Cloning Kit连接850 bp(40 ng)粘性末端片段图。
注:A)载体和片段均来自南京某高校;B)插入片段PCR鉴定电泳图
Hieff Clone® Universal Zero TOPO TA/Blunt Cloning Kit连接1150 bp(20 ng)粘性末端片段图。
注:A)载体和片段均来自南京某高校;B)插入片段PCR鉴定电泳图
Hieff Clone® Universal Zero TOPO TA/Blunt Cloning Kit连接2000 bp(50 ng)粘性末端片段图。
从以上产品数据大家可以看到,翌圣新款通用型TOPO克隆试剂盒的连接效率高,阳性克隆率好,稳定性强,客户反馈好,证明翌圣的TOPO克隆试剂盒是一款性能优异的产品。选购我们,不会有“错”!全新上线的TOPO克隆试剂盒助您在克隆连接上顺心顺意。
新品上市-反馈有礼
使用翌圣本款新品进行测试,按要求提交实验结果,填写实验反馈,即可参与活动获得奖品!小夜灯/计时器/太阳伞三选一哦!
另外,如果小伙伴们再附加上其他同类产品比对,数据详尽,就可将奖品升级成富光不锈钢保温杯一个哦,奖品有限,先到先得,小伙伴们快来参与吧~

提交时间:
10月12日-11月12日
结果公布:
翌圣工作人员将在收到反馈后的3个工作日内,通过邮件联系获奖者,并通过当地业务员送达礼品。
反馈方式:
扫描下方二维码或点击链接,按要求填写新品体验反馈即可获得精美礼品一份。

0元试用申请通道:
若小伙伴没有这款通用型TOPO克隆试剂盒,可以长按扫描下方二维码或点击链接,申请0元试用装~

10906ES商品订购通道
| 产品定位 |
名称 |
货号 |
规格 |
| 兼容TA/平末端克隆 |
Hieff Clone® Universal Zero TOPO TA/Blunt Cloning Kit |
5 T/20 T |
相关产品
| 产品定位 |
名称 |
货号 |
规格 |
| 高保真PCR |
2×Hieff Canace® Plus PCR Master Mix(With Dye) |
1 mL/5×1 mL |
|
| 2×Hieff Canace® AdvanceFast PCR Master Mix (With Dye) |
1 mL/5×1 mL |
||
| 2×Hieff Canace® Gold PCR Master Mix |
1 mL/5×1 mL |
||
| 核酸染料 |
YeaRed Nucleic Acid Gel Stain(10,000× in Water) YeaRed核酸染料(10,000× 水溶液) |
500 μL |
|
| YeaGreen Nucleic Acid Gel Stain (10,000×in Water) |
500 μL |
||
| 琼脂糖 |
Agarose琼脂糖 |
100 g/500 g |
|
| High Sieving Agarose 高分辨率琼脂糖(PCR级) |
5 g/25 g |
||
| DNA纯化回收试剂盒 |
MolPure® Gel Extraction Kit 琼脂糖凝胶回收试剂盒 |
50 T/200 T |
|
| 感受态 |
DH5α Fast Chemically Competent Cell F DH5α化学感受态 |
10×100 μL |
|
| DH5α Chemically Competent Cell DH5α 化学感受态细胞 |
10×100 μL |
||
| 快速PCR |
2×Hieff® Ultra-Rapid HotStart PCR Master Mix(with Dye) |
1 mL/5×1 mL |